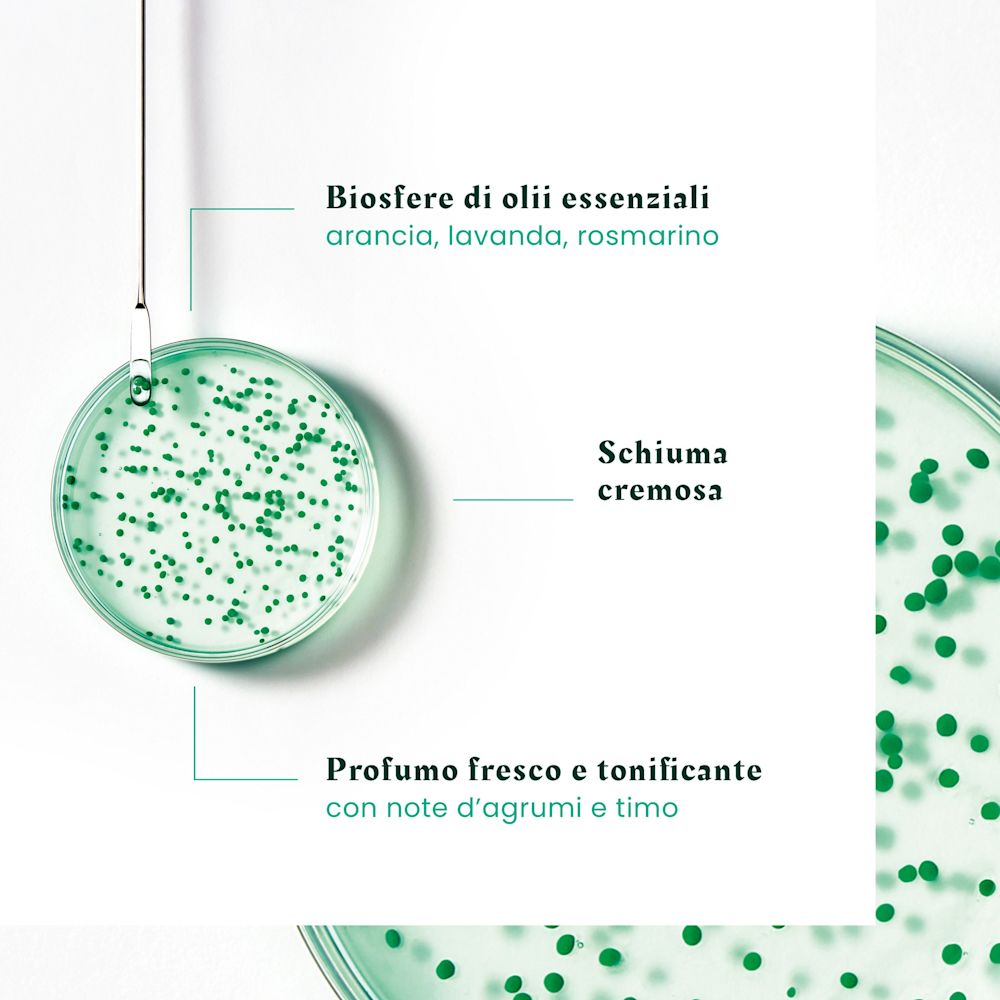
985649906 - FORTICEA SHAMPOO FORTIFICANTE E RIVITALIZZANTE 2023 200 ML - 4745720_4.jpg

Rene Furterer Forticea Shampoo Fortificante E Rivitalizzante 200ml
Tutti i prezzi includono l'IVA.
Disponibile a magazzino
Registrati per attivare un extra sconto del 5% su un ordine a tua scelta
Quantità: 1
Costo a confezione: 15,04 €
Registrati per attivare un extra sconto del 5% su un ordine a tua scelta
Informazioni prodotto
SCHEDA TECNICA
Rene Furterer Forticea Shampoo Fortificante e Rivitalizzante 200ml
Lo Shampoo fortificante rivitalizzante è formulato per tutti i tipi di capelli. Associa il Guaranà, potente energizzante naturale, con Vitamine B5 e B3, chiamata anche Niacinamide, e con i preziosi poteri delle Biosfere che racchiudono un cocktail di Oli essenziali stimolanti, per risvegliare la forza dei capelli. Fin dalla radice, l'apporto di vitamine ed elementi energetici è intensificato per una fibra del capello più forte, più resistente, più bella. I capelli sono rinforzati e pieni di energia. Leggeri e facili da acconciare, i capelli hanno una buona tenuta. 97% di ingredienti di origine naturale. Senza silicone, senza tensioattivi solfatati. Formula biodegradabile*.
*Secondo il test OECD 301B. Per la raccolta differenziata degli imballaggi dopo l'utilizzo, consultare la pagina del prodotto sul sito di marca.
Benefici
- DETERGE DELICATAMENTE: formulato con il 97% di ingredienti di origine naturale e senza tensioattivi solfatati, questo shampoo purifica delicatamente il cuoio capelluto e rafforza i capelli fin dalle radici.
- FORTIFICA E RIVITALIZZA: arricchito in Estratto di Guaranà, un energizzante naturale, Vitamine e Olii essenziali, aiuta i capelli a ritrovare forza e vitalità. Energizzati, i capelli sono leggeri e facili da mettere in piega.
- FORMULA SENSORIALE: la consistenza in gel trasparente, ricca di preziose biosfere di Olii Essenziali, avvolge i capelli in una fragranza fresca e tonificante, con note di agrumi e timo.
Modo d'uso
Emulsionare sul cuoio capelluto bagnato e massaggiare delicatamente con movimenti circolari. Lasciare in posa da 1 a 3 minuti. Risciacquare.
Avvertenze
Risciacquare in caso di contatto con gli occhi.
Ingredienti
Water (Aqua)*. Lauryl Glucoside*. Sodium Cocoyl Alaninate*. Coco-Betaine. Agar*. Algin*. Benzoic Acid. Caffeine. Calcium Gluconate. Cellulose*. Cellulose Gum*. Chromium Hydroxide Green (Ci 77289). Chromium Oxide Greens (Ci 77288). Citric Acid*. Citrus Aurantium Dulcis (Orange) Oil (Citrus Aurantium Dulcis Oil)*. Fragrance (Parfum). Gluconolactone*. Glycerin*. Green 3 (Ci 42053). Hydroxypropyl Guar Hydroxypropyltrimonium Chloride. Lavandula Angustifolia (Lavender) Oil (Lavandula Angustifolia Oil)*. Lavandula Hybrida Oil*. Limonene*. Linalool*. Maltodextrin*. Methyl Glucose Dioleate. Niacinamide. Panthenol. Pantolactone. Paullinia Cupana Seed Extract*. Propanediol. Rosmarinus Officinalis (Rosemary) Leaf Oil (Rosmarinus Officinalis Leaf Oil)*. Sodium Benzoate. Talc. Tocopherol. Tocopheryl Acetate. Yellow 5 (Ci 19140).
Formato
200ml